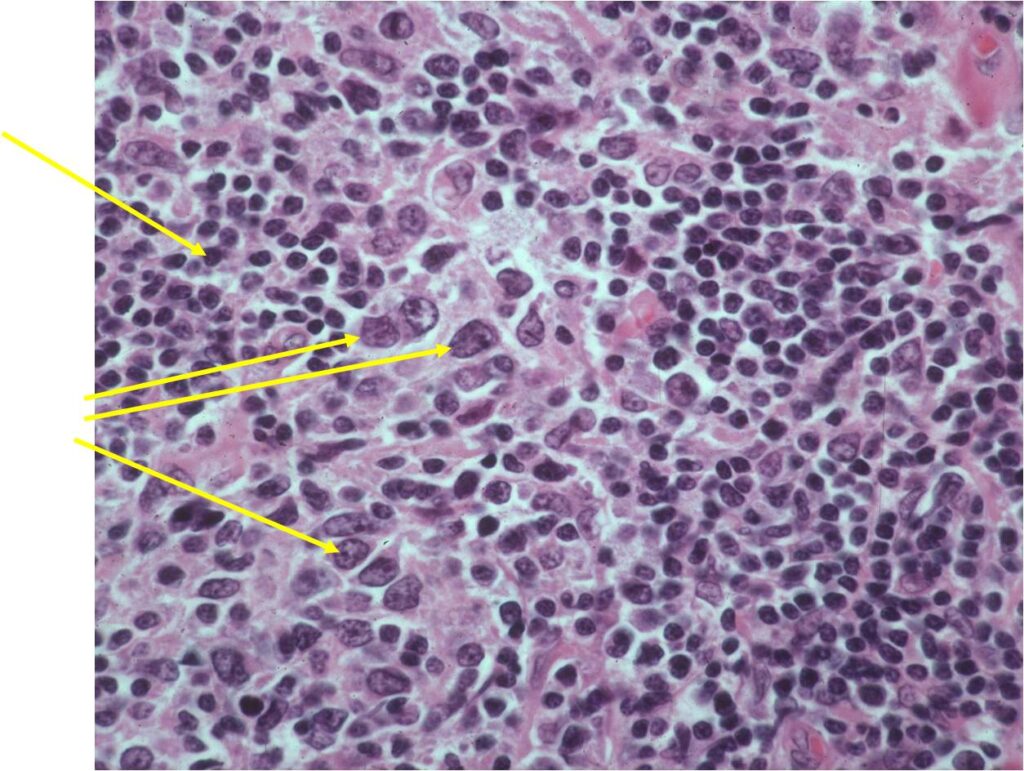

General Information
- Primary lymphoma of bone is defined as lymphoma arising within the medullary cavity of a bone in the absence of lymph node or organ involvement for at least 6 months after diagnosis
- Primary lymphoma of bone is rare (3% of primary bone tumors) and most lymphomas that involve bone are metastatic from lymph node. If a lymphoma of bone is diagnosed one must look for another site.
- Most primary lymphomas of bone are Non Hodgkin’s, large cell lymphomas
- In U.S. majority are B-cell proliferations
- Must rule out presence of extraskeletal disease
- May be misdiagnosed as chronic osteomyelitis
Clinical Presentation
Signs/Symptoms:
- Localized dull or aching pain
- May have palpable mass or swelling
- Usually no general symptoms and appear healthy
- Pathological fractures in 25% of cases
- Prevalence: Male predilection (1.5:1)
Age:
- Broad age range
- Most occur after second decade with 50% occurring above 40 years
- Rare in children
Sites:
- Any bone can be involved
- Lower extremities involved most often especially femur and pelvis
- More common in appendicular than axial skeleton (opposite of metastatic lymphoma)
Radiographic Presentation
- Permeative or moth eaten bone destruction (55%)
- Geographic (11%); Blow out (1%); Blastic (2%); Normal XR (5%)
- Metadiaphysis (75%)
- Periosteal reaction—may look benign
- Interrupted or solid single layer (66%)
- Onion Skin 10%
- Sunburst 2%
- Soft tissue mass— by CT (80%); by MRI (100%)
- Pathologic Fracture (22%)
- Sequestra (16%)
- Cross Joint (5%)
- Diff Dx:
- Metastatic Lymphoma
- Ewings
- Neuroblastoma
- Rhabdomyosarcoma
- Osteomyelitis
- Eosinophilic Granuloma

Permeative Lesion of Proximal Tibia with Pathological Fracture

Permeative/Motheaten Lesion with Pathologic Fracture

Permeative Moth eaten Lesion

Permeative Lesion

Permeative/Moth eaten lesion Reactive sclerosis (mixed lysis and sclerosis) Slight periosteal reaction

T2 Weighted MRI

TI Weighted MRI





Gross Pathology
- Diffuse infiltrative growth pattern with soft tissue extension
- Intraosseous component
- Mixture of bone spicules and marrow fat as lesion permeates through the medullary canal and has an indistinct margin
- Extraosseous tissue
- Tan or white, resembles lymphomatous lymph nodes
- Areas of necrosis, hemorrhage, and cystic degeneration are present
Microscopic Pathology
- Diffuse growth pattern
- Mixture of small lymphocytic cells and larger histiocytic components (Large Malignant B Cells in most cases)
- Cells and no matrix
- Nuclei
- Vary in shape and size
- Grooved vesicular nuclei
- Prominant nucleoli
- Cytoplasmic glycogen is absent
- Complex reticulin framework
- Prominent fibroblastic component
- CD5 and Leukocyte Common Antigen Positive
- CD3+ and CD45+ for B Cell Lymphoma; CD3+ for Rare T-Cell

Differential Diagnosis
- Ewing Sarcoma
- Chronic Osteomyelitis
- Leukemia
Treatment
- Chemotherapy and radiation
- If truly an isolated primary lymphoma of bone, limb sparing surgery may be considered instead of or in conjunction with radiation
- Surgical resections to treat residual or recurrent tumors after radiation
- Amputation only recommended when lesions are unresponsive to radiation or recur and are not amenable to limb sparing surgery for various reasons
Prognosis
Patients with:
- Monostotic disease & no soft tissue involvement
- 58% 5-year and 53% 10-year survival
- Multifocal bony disease
- 42% 5 year and 35% 10 year survival
- Osseous lymphoma with lymph node involvement
- 22% 5-year and 12% 10-year survival
- Chemotherapy increases survival rates (88% disease free survival at 7 years) of patients with primary lymphoma of bone
- Has best prognosis of all osseous malignancies except for low grade intraosseous and parosteal osteosarcoma
- Possible better prognosis for lymphomas with cleaved nuclei as compared to noncleaved, immunoblastic or pleomorphic variants